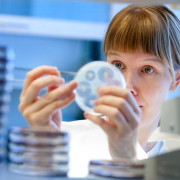

Opetushoitaja, Ortopedian ja traumatologian osasto S5A, Siltasairaala
Pages
Yrityksen sijainnit
HUS työnantajana
HUSissa olet elämäntyössä
HUS on työpaikka, jossa voit kasvaa ammattilaisena sekä tehdä merkityksellistä työtä osaamistasi arvostavassa ja kansainvälisesti korkeatasoisessa terveydenhuollon yhteisössä. HUS Helsingin yliopistollinen sairaala on Suomen suurin terveydenhuoltoalan toimija ja maan toiseksi suurin työnantaja. Meillä työskentelee lähes 27 000 ammattilaista potilaiden parhaaksi yli 300 erilaisessa ammatissa.
Ainutlaatuisia työtehtäviä terveydenhuollon eturintamassa
Suomen johtavana sairaalakokonaisuutena HUS tarjoaa ainutlaatuisia työtehtäviä monien eri alojen ammattilaisille. Vastaamme erikoissairaanhoidon järjestämisestä Uudenmaan alueella. Lisäksi meille on keskitetty valtakunnallisesti useiden harvinaisten ja vaikeiden sairauksien hoito. Yliopistollisena sairaalana tutkimme ja kehitämme jatkuvasti hoitomenetelmiämme sekä toimintaamme.
Vaikuttavaa ja ammatillisesti kehittävää työtä eri alojen ammattilaisille
Eri aloja edustavat ammattilaiset muodostavan joukon, jossa jokaisella on tärkeä paikkansa yhteiskuntamme vaikuttajana, vastuunkantajana ja terveydenhuollon takaajana. Haluamme tarjota työntekijöillemme parhaat mahdollisuudet olla mukana kehittämässä hyvinvoivaa ja terveempää yhteiskuntaa. Ura HUSissa pitää sisällään jatkuvaa oppimista monipuolisten työtehtävien ja urapolkujen myötä.
Yhteisöllisyyttä ja yhdenvertaisuutta moniammatillisessa tiimissä
Moniammatillisuus on vahvuutemme. Rakennamme arkea luottamalla tiimien ammattitaitoon ja luomalla mahdollisuuksia johtaa omaa työtä. Vaikka HUS on suuri, arjen työyhteisösi koostuu kannustavista tiimikavereista ympärilläsi.
Henkilöstöetuja ja hyvinvointia kaikissa elämäntilanteissa
Tuemme työhyvinvointia liikunta- ja kulttuurieduilla sekä työsuhdematkaedulla. Tarjoamme sairaan lapsen hoitopalvelua sekä mahdollisuuden hankkia työsuhdeasunto ja vuokrata henkilöstöhintaan lomamökkejä. HUSista saat itsellesi savuttoman työpaikan.
Ura HUSissa
Kiinnostaako ura terveydenhuollossa? Tutustu avoimiin työpaikkoihimme ja löydä oma paikkasi HUSin huipputiimissä.
Inspiroidu HUSin ammattilaisten tarinoista. Lue, millaista on työskennellä Suomen johtavassa terveydenhuollon organisaatiossa.